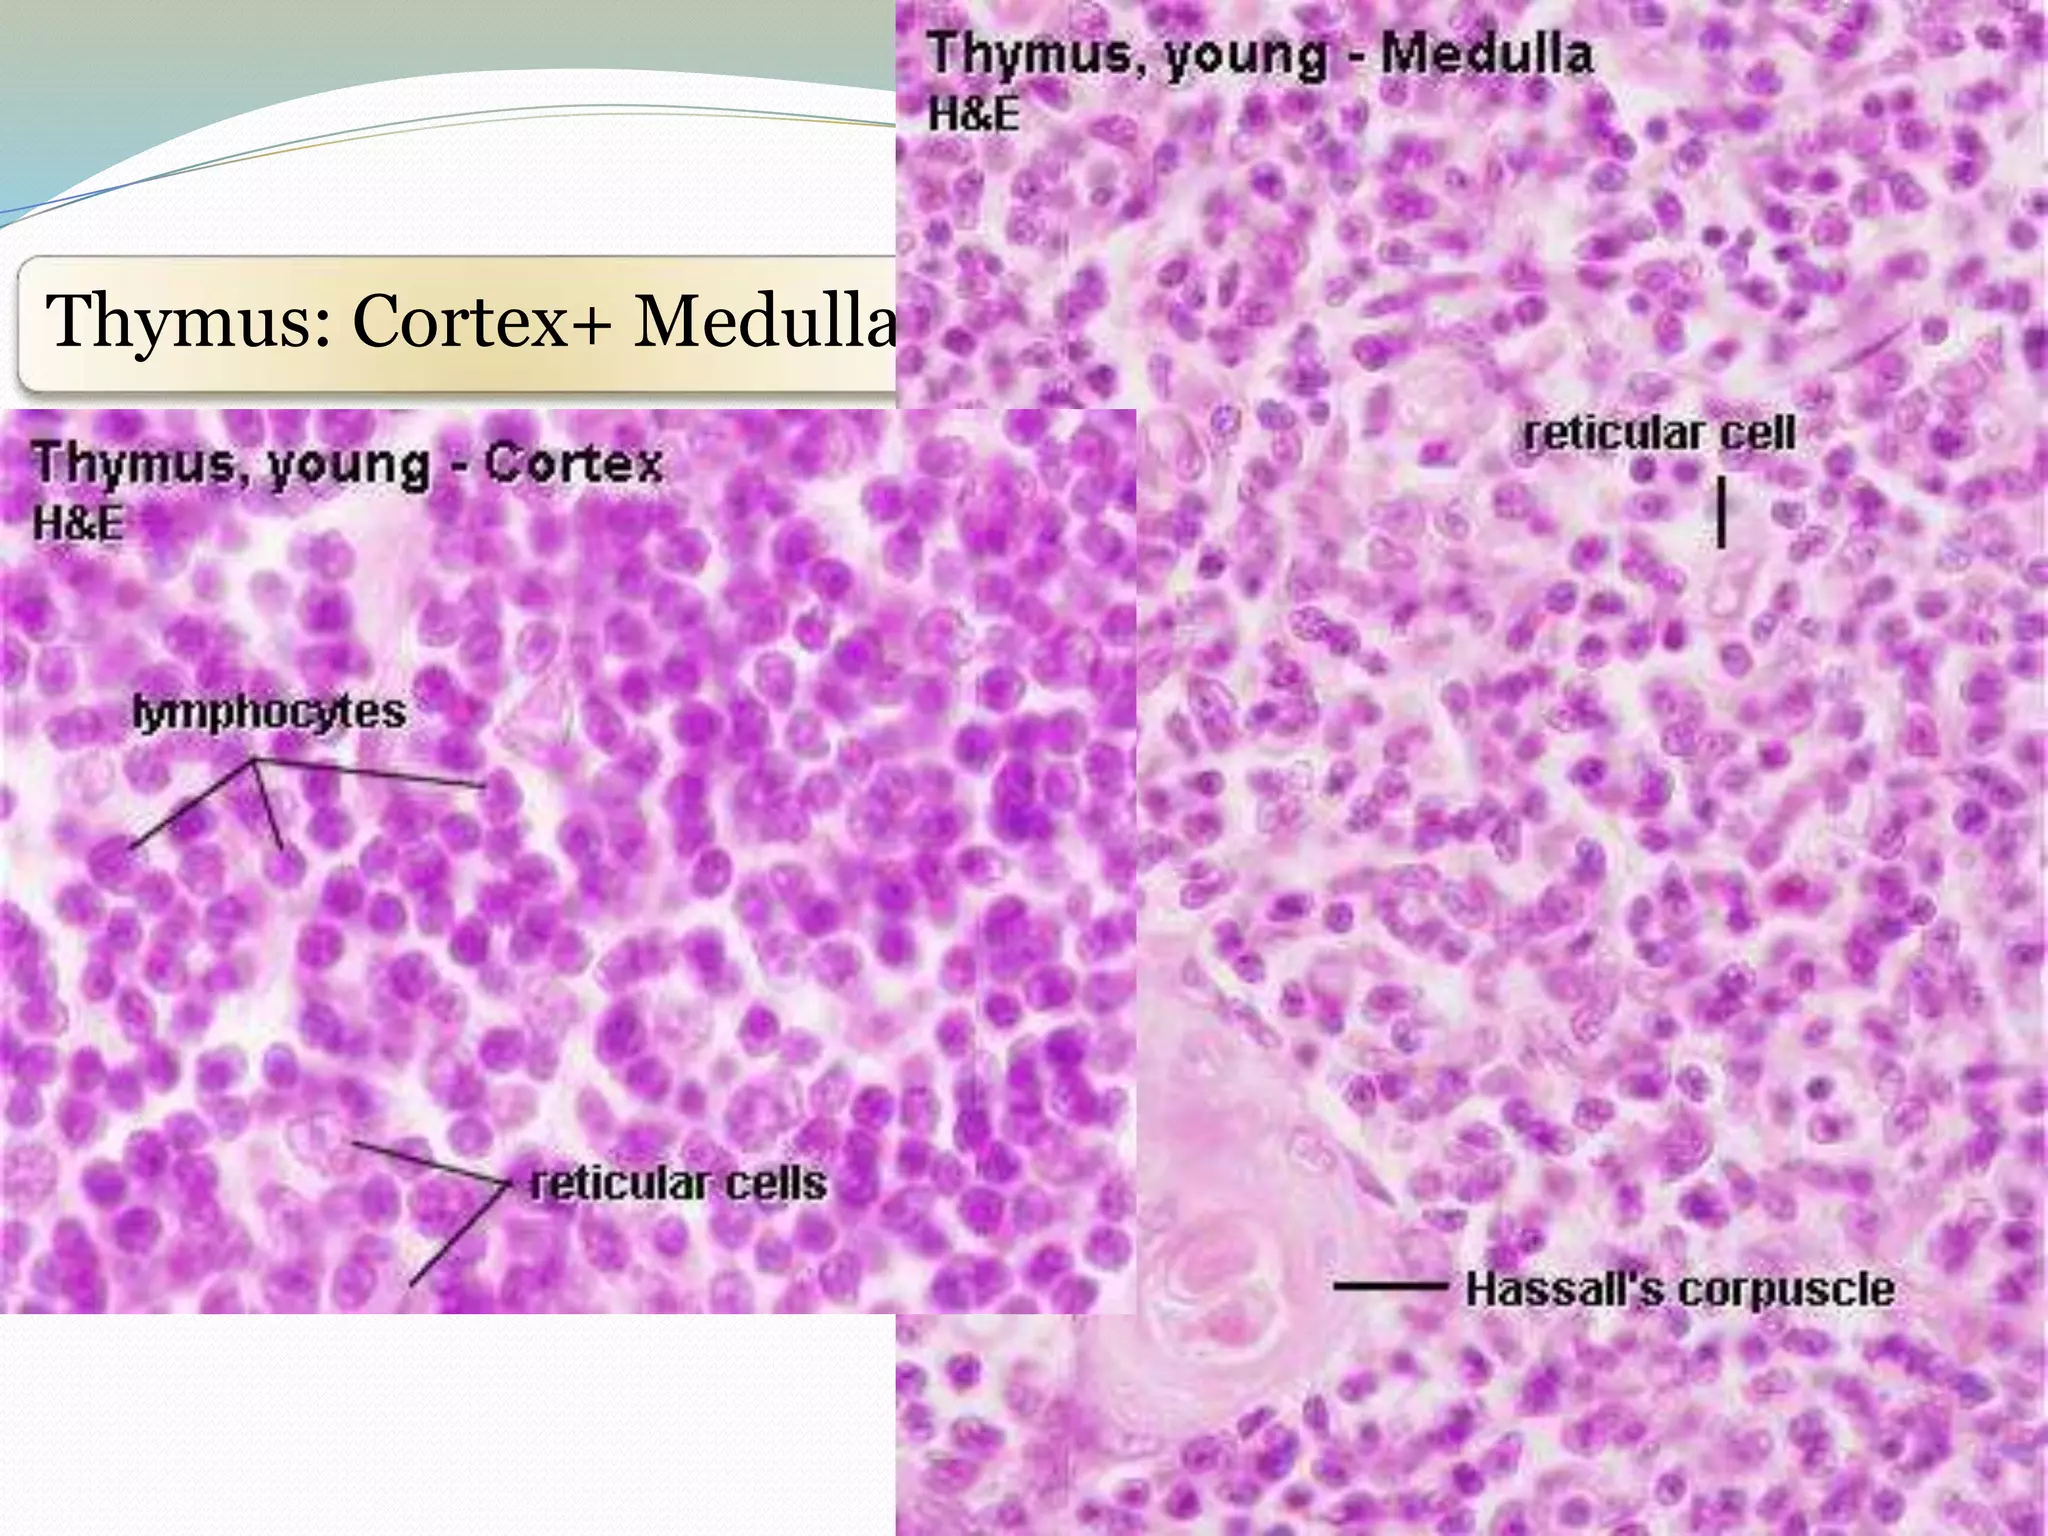
Thymus: Cortex+ Medulla

Lymphoid organs such as the bone marrow, thymus, lymph nodes, and spleen are involved in conducting immune responses. The bone marrow and thymus are primary lymphoid organs that produce naïve lymphocytes. Secondary lymphoid organs such as lymph nodes and the spleen facilitate interactions between antigens and lymphocytes. Tertiary lymphoid organs are sites of infection that immune cells must survey and regulate the influx of effector cells to. The document then discusses the cells and processes involved in the primary and secondary lymphoid organs.